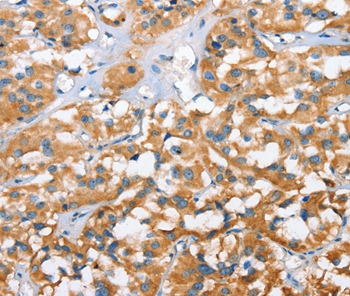

Immunohistochemistry of paraffin-embedded Human thyroid cancer tissue using CXCL14 Polyclonal Antibody at dilution 1:40
CXCL14 Polyclonal Antibody
E-AB-10342
Product group Antibodies
Overview
- SupplierElabscience
- Product NameCXCL14 Polyclonal Antibody
- Delivery Days Customer12
- Applications SupplierELISA IHC
- CertificationResearch Use Only
- Concentration0.6mg/ml
- Scientific DescriptionThis gene belongs to the cytokine gene family which encode secreted proteins involved in immunoregulatory and inflammatory processes. The protein encoded by this gene is structurally related to the CXC (Cys-X-Cys) subfamily of cytokines. Members of this subfamily are characterized by two cysteines separated by a single amino acid. This cytokine displays chemotactic activity for monocytes but not for lymphocytes, dendritic cells, neutrophils or macrophages. It has been implicated that this cytokine is involved in the homeostasis of monocyte-derived macrophages rather than in inflammation.
- UNSPSC12352203